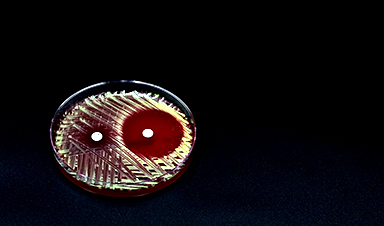

COVID-19 didn't just claim lives directly—it reshaped mortality patterns worldwide. A major international study found that life expectancy plummeted across most of the 24 analyzed countries, with additional deaths from cardiovascular disease, substance abuse, and mental health-related issues.
While some countries, like Japan and South Korea, fared better, Eastern Europe and the U.S. saw devastating losses. Interestingly, cancer mortality continued to decline, suggesting some medical services remained intact. The findings stress the urgent need for stronger healthcare systems to withstand future crises.
COVID-19's Broad Impact on Global Mortality
A global study, co-authored by DPhil student Antonino Polizzi and Marie Sklodowska-Curie Fellow Dr. José Manuel Aburto, examined how the COVID-19 pandemic affected mortality across 24 countries.
Researchers from the University of Oxford, Australian National University, and the London School of Hygiene & Tropical Medicine analyzed cause-of-death data from these countries before and during the pandemic.
Staggering Declines in 2020 and 2021
Their findings revealed a sharp drop in life expectancy in 2020 for nearly all countries studied, with only four exceptions. The United States saw the steepest decline, with life expectancy for males falling by 2.1 years.
In 2021, life expectancy continued to decline in most countries. The most severe losses were recorded in Bulgaria for females and Latvia for males, both experiencing declines of more than two years.
COVID-19's Lasting Mortality Effects
Lead author Antonino Polizzi said, "This study explores the direct and indirect effects of the COVID-19 pandemic on mortality across the world, and highlights that life expectancy losses had still not returned to pre-pandemic levels in several countries by 2022."
The study found that, in addition to COVID-19 deaths, increased mortality attributed to cardiovascular disease was a major contributor to life expectancy losses during the first two years of the pandemic, particularly in Russia and Eastern Europe.
Eastern Europe Hit Hard by Heart Disease
In 2020, cardiovascular disease-related losses were greatest in Russia which experienced losses of 5.3 months, while Bulgaria experienced cardiovascular disease-related losses of 5.5 months in 2021. The authors suggest that this could have been due to lapses in prevention or treatment of cardiovascular disease, or undercounted COVID-19 deaths.
Substance Abuse and Mental Health Toll
The study also found increased mortality from substance abuse and mental health-related causes in some countries during the pandemic. The USA and Canada saw continued increases in drug-related deaths, contributing to life expectancy declines.
Alcohol-related mortality also increased, with Latvia experiencing significant life expectancy losses. However, suicide and accident mortality typically declined during the pandemic years.
East Asia's Resilience Amid the Crisis
Japan and South Korea experienced minimal life expectancy losses during the pandemic and were the exception to most of these trends. However, females in Japan saw comparatively large losses from suicide mortality in 2020.
More positively, cancer mortality generally continued to decline in most countries. The authors speculate that cancer care was less disrupted than expected during the pandemic, or that people with cancer were more susceptible to COVID-19 mortality which was then not counted as a cancer death.
Lessons for the Future of Global Healthcare
The study concludes by underscoring the need for robust healthcare systems capable of handling crises without compromising care for other conditions. It also highlights the importance of targeted public health interventions to address the varied impacts across different countries and age groups.
Dr. José Manuel Aburto said, "This study highlights the extent to which the COVID-19 pandemic impacted other causes of death, and the need to analyze different diseases and causes of death in a post-pandemic context to identify factors that can improve global healthcare systems."
Reference: "Indirect effects of the COVID-19 pandemic: A cause-of-death analysis of life expectancy changes in 24 countries, 2015 to 2022" by Antonino Polizzi, Luyin Zhang, Sergey Timonin, Aashish Gupta, Jennifer Beam Dowd, David A Leon and José Manuel Aburto, 19 December 2024, PNAS Nexus.
DOI: 10.1093/pnasnexus/pgae508
News
Older chemical libraries show promise for fighting resistant strains of COVID-19 virus
SARS‑CoV‑2, the virus that causes COVID-19, continues to mutate, with some newer strains becoming less responsive to current antiviral treatments like Paxlovid. Now, University of California San Diego scientists and an international team of [...]
Lower doses of immunotherapy for skin cancer give better results, study suggests
According to a new study, lower doses of approved immunotherapy for malignant melanoma can give better results against tumors, while reducing side effects. This is reported by researchers at Karolinska Institutet in the Journal of the National [...]
Researchers highlight five pathways through which microplastics can harm the brain
Microplastics could be fueling neurodegenerative diseases like Alzheimer's and Parkinson's, with a new study highlighting five ways microplastics can trigger inflammation and damage in the brain. More than 57 million people live with dementia, [...]
Tiny Metal Nanodots Obliterate Cancer Cells While Largely Sparing Healthy Tissue
Scientists have developed tiny metal-oxide particles that push cancer cells past their stress limits while sparing healthy tissue. An international team led by RMIT University has developed tiny particles called nanodots, crafted from a metallic compound, [...]
Gold Nanoclusters Could Supercharge Quantum Computers
Researchers found that gold “super atoms” can behave like the atoms in top-tier quantum systems—only far easier to scale. These tiny clusters can be customized at the molecular level, offering a powerful, tunable foundation [...]
A single shot of HPV vaccine may be enough to fight cervical cancer, study finds
WASHINGTON -- A single HPV vaccination appears just as effective as two doses at preventing the viral infection that causes cervical cancer, researchers reported Wednesday. HPV, or human papillomavirus, is very common and spread [...]
New technique overcomes technological barrier in 3D brain imaging
Scientists at the Swiss Light Source SLS have succeeded in mapping a piece of brain tissue in 3D at unprecedented resolution using X-rays, non-destructively. The breakthrough overcomes a long-standing technological barrier that had limited [...]
Scientists Uncover Hidden Blood Pattern in Long COVID
Researchers found persistent microclot and NET structures in Long COVID blood that may explain long-lasting symptoms. Researchers examining Long COVID have identified a structural connection between circulating microclots and neutrophil extracellular traps (NETs). The [...]
This Cellular Trick Helps Cancer Spread, but Could Also Stop It
Groups of normal cbiells can sense far into their surroundings, helping explain cancer cell migration. Understanding this ability could lead to new ways to limit tumor spread. The tale of the princess and the [...]
New mRNA therapy targets drug-resistant pneumonia
Bacteria that multiply on surfaces are a major headache in health care when they gain a foothold on, for example, implants or in catheters. Researchers at Chalmers University of Technology in Sweden have found [...]
Current Heart Health Guidelines Are Failing To Catch a Deadly Genetic Killer
New research reveals that standard screening misses most people with a common inherited cholesterol disorder. A Mayo Clinic study reports that current genetic screening guidelines overlook most people who have familial hypercholesterolemia, an inherited disorder that [...]
Scientists Identify the Evolutionary “Purpose” of Consciousness
Summary: Researchers at Ruhr University Bochum explore why consciousness evolved and why different species developed it in distinct ways. By comparing humans with birds, they show that complex awareness may arise through different neural architectures yet [...]
Novel mRNA therapy curbs antibiotic-resistant infections in preclinical lung models
Researchers at the Icahn School of Medicine at Mount Sinai and collaborators have reported early success with a novel mRNA-based therapy designed to combat antibiotic-resistant bacteria. The findings, published in Nature Biotechnology, show that in [...]
New skin-permeable polymer delivers insulin without needles
A breakthrough zwitterionic polymer slips through the skin’s toughest barriers, carrying insulin deep into tissue and normalizing blood sugar, offering patients a painless alternative to daily injections. A recent study published in the journal Nature examines [...]
Multifunctional Nanogels: A Breakthrough in Antibacterial Strategies
Antibiotic resistance is a growing concern - from human health to crop survival. A new study successfully uses nanogels to target and almost entirely inhibit the bacteria P. Aeruginosa. Recently published in Angewandte Chemie, the study [...]
Nanoflowers rejuvenate old and damaged human cells by replacing their mitochondria
Biomedical researchers at Texas A&M University may have discovered a way to stop or even reverse the decline of cellular energy production—a finding that could have revolutionary effects across medicine. Dr. Akhilesh K. Gaharwar [...]